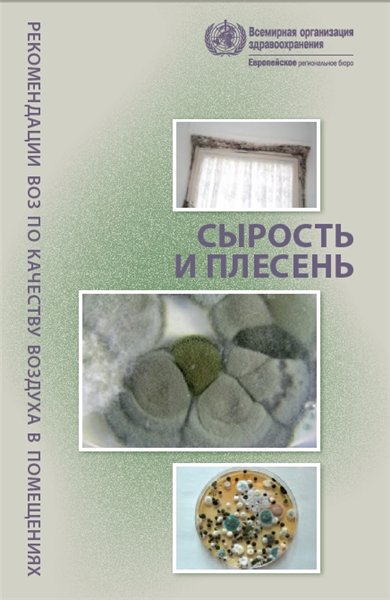
Рекомендации ВОЗ по качеству воздуха в помещениях: сырость и плесень

Книга включает посвященные Западному Ириану очерки "Каннибалы, мои товарищи" и "Новая Гвинея", публикуемые с некоторыми сокращениями. Автор стремится объективно рассказать о жизни различных местных племен. В очерках Лундквиста нашел выражение его глубокий протест против бытующего в буржуазной литературе изображения коренных обитателей Западного Ириана кровожадными дикарями - каннибалами.

Современный человек пользуется картами практически ежедневно: карты украшают стены школ, они помогают нам ориентироваться на местности, находить кратчайший путь из одного пункта в другой, изучать историю, географию, экономику и ряд других наук. Карты - важный рабочий инструмент для некоторых специалистов: моряков, летчиков, машинистов, топографов и проч. Но много ли мы знаем о том, как создаются карты? Для чего существует такое количество разнообразных карт и насколько все они точны? Прочитав эту книгу, вы узнаете множество новых и любопытных фактов о геометрии карт.
20 лет назад казалось, что во Вселенной есть только одна планета, способная поддерживать жизнь. Сегодня мнение астрономов изменилось. Мы расскажем о поисках близнеца Земли.
В условиях достаточной влажности воздух в помещениях загрязняют сотни видов бактерий и грибков – особенно плесень. Наиболее важными последствиями такого загрязнения являются увеличение распространенности респираторных симптомов, аллергии и астмы, а также нарушения иммунной системы. Предупреждение (или минимизация) постоянной сырости и роста микроорганизмов на внутренних поверхностях помещений и на строительных конструкциях – это важнейшее средство предупреждения их вредного воздействия на здоровье людей.

Рассмотрены основы радиометрии некогерентного и когерентного оптического излучения как области измерений. Наряду с основными положениями метрологии описаны методы и средства измерений величин, характеризующих процессы распространения оптического излучения в пространстве, а также в различных материалах и веществах. Особое внимание уделено таким распространенным видам измерений, как спектрорадиометрия, фотометрия, спектрофотометрия, цветовые и поляризационные измерения, измерения излучательных параметров и характеристик лазерного излучения.

Журнал поможет пополнить коллекцию купюрами пяти континентов, позволит заглянуть в историю народов мира, расшифрует денежные изображения и символы. Коллекция редких купюр и монет, являющаяся дополнением журнала, позволит подержать в руках афганские банкноты, купюры времён правления Хусейна, восхититься экзотичностью денежных знаков Замбии, своеобразием тайских и индийских монет.

Книга посвящена рыбам, обитающим в прибрежной зоне Крымского полуострова в Черном и Азовском морях. Рассматривается история изучения морской ихтиофауны, анализируется процесс ее формирования в связи с бурным геологическим прошлым региона. Приводятся описания 116 видов рыб, включающие характерные признаки вида, его распространение, биологию, экологию, промысловую и пищевую значимость, охранный статус, а также авторские фотографии большинства видов. Дается краткая характеристика региональной ихтиофауны различных участков крымского прибрежья, анализируются структура и расположение характерных ихтиоценов. Указываются основные антропогенные факторы, оказывающие негативное влияние на ихтиофауну Крыма.

Фрактальные структуры живого рассматриваются в аспекте направленности, запрограммированности эволюционного процесса. Для обоснования этих положений анализируется альтернативность воззрений, с одной стороны, дарвинизма, синтетической теории эволюции, а с другой - номогенеза, а также ряда других теорий о природе биологической эволюции в рамках концепции фракталов.
В начале XIX века по Тверской губернии прокатились слухи, что в усадьбе Николая Львова под Торжком происходит что-то невероятное… Даже в засушливые годы там собирали богатый урожай, а крестьяне выращивали промышленный сорт винограда. Поговаривали, что все это стало возможным благодаря неким пирамидам, которые Львов построил у себя в поместье и в двух ближайших имениях. Искатели решили разобраться, для чего Николай Львов возвел эти таинственные сооружения.

Сборник представляет собой популярное изложение принципов работы с одним из основных инструментов информатики — персональным компьютером. Описываются устройство персонального компьютера, основные приемы программирования на языках Бейсик и Лого, методы решения прикладных задач. Рассматриваются особенности применения персональных компьютеров в учреждениях, на производстве и дома.

Международный научно-популярный журнал по астрономии и космонавтике в доступной форме профессионально отражает и комментирует события, происходящие на переднем крае современной науки о Вселенной. Рассчитан на самый широкий круг читателей, которые интересуется данной тематикой.
3 серии
Когда в Европе господствовали племена варваров, на территории Китая уже существовала развитая цивилизация. Чтобы понять могущество народа, зачастую надо изучить его историю, Китай не исключение. Если верить легенде, основатель первой китайской династии Ся, был воин по имени Юй. От династии Ся свой род ведет весь китайский народ.

Дэвид Аттенборо отправляется в эпическое путешествие длиной 500 миллионов лет и исследует невероятный скачок в развитии позвоночных, породивший самых крупных, быстрых и умных существ, когда-либо живших на планете. Сначала он отправляется в Китай, страну, в которой он давно мечтал побывать, чтобы больше узнать о животных древности. Именно они считаются ключевыми недостающими звеньями в цепи нашей эволюции.

В течение жизни человек сталкивается с множеством разных задач. Какие-то из них оказываются элементарными, над решением других приходится серьезно подумать. Некоторые задачи, условия которых сформулированы еще сотни лет назад, не решены до сих пор. Эта книга - уникальный сборник величайших задач прошлого и современности. Работая над ее созданием, автор прислушивался к мнению научного сообщества: в издание включены только те задачи, которые большинство специалистов считают важнейшими в математике. Каждая из них - своеобразная бифуркационная точка, от которой зависит путь дальнейшего развития науки.

Качественно новый научно-познавательный журнал «проникает» в мир науки и показывает его изнутри, рассказывая о самых последних и актуальных событиях из мира науки и технологий, представляя новости и репортажи изо всех уголков планеты: от российского Сколково до американского NASA. Будет интересен всем, и студентам, и профессорам различных областей.

Аудиоверсия книги молодого научного журналиста Аси Казанцевой - об "основных биологических ловушках, которые мешают нам жить счастливо и вести себя хорошо". Опираясь по большей части на авторитетные научные труды и лишь иногда - на личный опыт, автор увлекательно и доступно рассказывает, откуда берутся вредные привычки, почему в ноябре так трудно работать и какие вещества лежат в основе "химии любви".

Пиво - один из древнейших напитков человечества, многие считают его самым популярным на планете. Классическое пиво по сей день делают из тех же ингредиентов, что и сотни лет назад, а вот процессы производства изменились до неузнаваемости. Традиционный состав пива - это четыре компонента: вода, дрожжи, шишки хмеля, солод.
3 серии
Можно ли доверять народной медицине? Почему официальная медицина не признает эту методику? Многие люди скептически относятся к рецептам сохранившимся от бабушек и передаваемых по наследству. Давайте посмотрим на данное лечение с медицинской точки зрения, главный критерий отбора подобных рецептов - проверено на себе. Мы расскажем о реальных случаях, когда народная медицина действительно помогла людям.

Книга посвящена разработке научных основ новой науки, изучающей закономерности возникновения, трансформации и отторжения продуктов конечного выделения объектов природы и человеческого общества - так называемых экскретов, влияние которых на нашу жизнь невозможно переоценить. Особенно заметно это влияние стало проявляться от группы "мусорных экскретов": отходов, отбросов, мусора.

От побережья Ньюфаундленда, окутанного туманом, до пустынь Северной Америки и тропических джунглей Квинсленда Дэвид Аттенбро в фильме "Первая жизнь" ищет доказательство в окаменелостях и животных невероятного периода истории Земли полмиллиарда лет назад, когда животные впервые появились в океанах. От первых глаз, которые видели, до первых хищников, которые убивали, и первых конечностей, которые шагали по суше, это были создания, которые развили черты и способности, позволяющие всем животным, даже нам, выживать в наши дни. Это история, которую можно рассказать только сейчас, поскольку найденные за последние несколько лет ошеломляющие окаменелости по всему миру изменили наше понимание самых первых форм жизни, а современная технология позволяет нам воссоздать первых животных и их окружение с помощью фотореалистичного компьютерного изображения.

